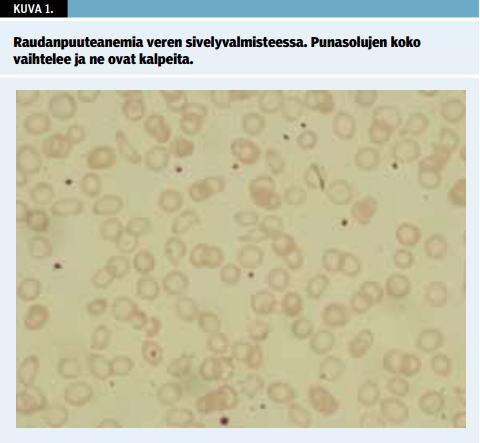

Ks. artikkelin pdf-versio «http://www.fimnet.fi/cl/laakarilehti/pdf/2014/SLL442014-2873.pdf»1 Lääkärilehden sivuilla (vaatii FiMnet-tunnuksen).
Rauta on elimistölle välttämätön alkuaine, mutta samalla potentiaalinen solumyrkky. Rauta-aineenvaihdunnan erikoisuus piilee sen yksisuuntaisuudessa: elimistöllä on monimutkainen ja herkkä koneisto rautatasapainon aistimiseen ja raudan imeytymisen säätelyyn, mutta ylimääräisen raudan poistojärjestelmä puuttuu (1).
Rautaa on elimistössä iän ja sukupuolen mukaan vaihdellen 15-45 mg painokiloa kohden. Valtaosa siitä on punasolujen hemoglobiinissa (70 %) ja lihassolujen myoglobiinissa (10 %). Viidesosa on varastoituneena maksasoluihin ja makrofageihin ferritiininä ja hemosideriininä. Rautaa tarvitaan myös useiden entsyymien toimintaan. Solutasolla rautatasapainon säätelystä vastaavat IRP-proteiinit (iron regulatory proteins) ja elimistön tasolla maksan tuottama hepsidiinihormoni (1).
Raudanpuute on lasten anemioiden selvästi tavallisin syy (2). Verenvuodot, hemolyyttiset kriisit ja sirppisoluanemiaan liittyvä sekvestraatio aiheuttavat nopeasti kehittyvän ja voimakasoireisen anemian. Leukemiaan liittyvä anemia kehittyy hitaasti blastisolukon syrjäyttäessä normaalin verenmuodostuksen. Infektioihin, kroonisiin sairauksiin ja luuytimen tuotantovikaan liittyvässä anemiassa (esim. aplastinen anemia) taudinkulku on niin ikään hidas ja potilas voi olla pitkään oireeton. Lapsen ohimenevä erytroblastopenia (transient erythroblastopenia of childhood, TEC) johtuu väliaikaisesta punasolutuotannon pysähtymisestä ja sen syntymiseen menee viikkoja.
Sikiön rauta on peräisin äidin verenkierrosta (3). Syntymän jälkeen punasolusynteesi taukoaa muutamaksi viikoksi ja punasolujen hajotuksesta vapautuva rauta varastoituu. Täysiaikaisena syntyneen lapsen rautavarastot riittävät noin puolen vuoden ikään saakka. Rauta imeytyy pohjukaissuolen yläosassa, mutta imeväisikäisen suolisto kykenee normaaliin raudan imeytymiseen vasta puolen vuoden tietämillä (4). Keskosilla rautavarastot ovat syntymähetkellä vajaat ja samanaikainen voimakas kasvu lisää raudan tarvetta. Raudanpuutteen ehkäisemiseksi heille aloitetaan rutiininomaisesti vuoden mittainen rautalisä.
Raudanpuutteen syykirjo vaihtelee lapsen iän mukaan (taulukko 1 «»1). Ensimmäisen ikävuoden jälkipuoliskolla, toisella ikävuodella ja murrosiässä ravitsemukselliset syyt ovat keskeisiä. Tällöin vallitsee epäsuhta raudan suuren tarpeen ja ravinnosta saatavan raudan määrän välillä. Ns. "maitoanemiassa" maito saa aikaan suolinukkavaurion ja lisäksi kalsium estää raudan imeytymistä. Kovin kasvispainotteisessa ruokavaliossa raudan saanti jää liian niukaksi.
Keliakiassa ja muissa ohutsuolen limakalvovaurioon johtavissa tautitiloissa raudan imeytyminen on häiriytynyt, ja erityisesti maahanmuuttajalapsilla saattaa olla helikobakteeri-infektio. Rautaa voidaan menettää verenvuodoissa (kuukautiset, nenä- ja suolistoverenvuoto). Infektiot ja inflammaatiot johtavat raudan hyväksikäytön häiriöön ja aiheuttavat raudanpuutteen luuytimessä, vaikka muualla elimistössä rautaa olisi yli tarpeen. Raudanpuuteanemia voi kehittyä myös siten, että rautaa kertyy epätarkoituksenmukaisesti esimerkiksi kasvainkudokseen tai keuhkoihin.
Elimistö tunnistaa rautavajeen monimutkaisen säätelyjärjestelmän avulla (1). Raudan imeytyminen tehostuu ja varastot otetaan käyttöön. Kun rautavarastot ovat tyhjentyneet ja raudasta on edelleen puutetta, alkavat "säästötoimet" kohdentua punasolujen kokoon ja väriin (kuva 1 «»2). Vasta viimeiseksi raudanpuute ilmenee hemoglobiinitason laskuna. Hoidon yhteydessä korjaantuminen tapahtuu päinvastaisessa järjestyksessä.
Anemiaan liittyvä kalpeus näkyy selvimmin limakalvoilla. Raudanpuuteanemia kehittyy hitaasti, ja väsyminen ja fyysisen suorituskyvyn heikkeneminen voivat ilmetä vasta hemoglobiinitason ollessa matala. Leikki-ikäinen lapsi jaksaa normaalit arkitoimet jopa hemoglobiinitason ollessa alle 50 g/l, vaikka anemia kuormittaakin sydäntä ja verenkiertoa ja johtaa syketason nousuun.
Lehmänmaidon liialliseen juomiseen voi liittyä suolivaurio, joka johtaa plasman albumiinipitoisuuden pienenemiseen ja turvotuksiin ja siten herättää epäilyt munuaissairaudesta. Suolivaurio korjaantuu, kun lehmänmaidon juomista rajoitetaan ja aloitetaan rautakorvaushoito.
Anamneesin ja statuslöydösten (myös kasvukäyrät) lisäksi verenkuvan tulkinta on anemian diagnostiikan kulmakivi (kuvio 1 «»3). Ensisijaisesti suositellaan laskimoverinäytteen tutkimista, sillä sormenpään kapillaarinäyte laimenee usein kudosnesteellä ja tulos on epäluotettava.
Punasolujen keskikoko (MCV) on raudanpuuteanemian yhteydessä ikäryhmän normaaliarvoihin verrattuna pienentynyt; alle 70 fl:n koko on poikkeava. MCV-arvoa tulkittaessa on huomattava, että leikki-ikäisillä MCV on normaalistikin pienempi kuin aikuisilla (yli 80 fl).
Jos kyse on maahanmuuttajasta (Välimeren seutu, Lähi- ja Kaukoitä), talassemiat ja hemoglobinopatiat ovat yleinen syy mikrosytääriseen anemiaan (taulukko 2 «»4). Punasolujen kokojakauma (RDW) on saatavilla nykyaikaisista verenkuva-analysaattoreista. Raudanpuutteen yhteydessä verenkierrossa on erikokoisia punasoluja ja kokojakauma on leveä (taulukko 2). RDW:n suurentuminen on herkin raudanpuutteen osoittaja perusverenkuvassa. Punasolujen absoluuttinen määrä (B-Eryt) on yleensä talassemioissa suurentunut, mutta raudanpuuteanemiassa normaalia pienempi.
Retikulosyyttimäärä on raudanpuuteanemian yhteydessä pieni tai normaali, mutta hoidon alettua se kasvaa nopeasti viitealueen yläpuolelle. Jos retikulosyyttimäärä on jo diagnoosivaiheessa suurentunut, on hyvä varmistaa, ettei samaan aikaan punasolujen hajoaminen ole lisääntynyt. Hemolyysin yhteydessä plasman haptoglobiiniarvo on pieni, bilirubiiniarvo ja laktaattidehydrogenaasitaso ovat suurentuneet. Autoimmuunihemolyyttisessä anemiassa (AIHA) Coombsin koe on positiivinen. Hemolyyttiset anemiat ovat yleensä normosytäärisiä tai lievästi makrosytäärisiä. Myös muiden verisolulinjojen tarkastelu on tärkeätä. Raudanpuutteen yhteydessä on usein reaktiivinen trombosytoosi, joka korjaaantuu muutamassa viikossa rautahoidon alettua. Pahanlaatuisten veritautien ja aplastisen anemian yhteydessä anemia on tyypillisesti normosytäärinen.
Elimistön rautavarastojen mittarina käytetään plasman ferritiinin määritystä. Ferritiinitaso on matala raudanpuutteen yhteydessä. Arvon jääminen alle 10 mg:n/l viittaa vajaisiin rautavarastoihin. Ferritiinin määrityksen virhelähteitä ovat samanaikaiset infektiot tai inflammaatiot, jotka voivat nostaa ferritiiniarvoa. Liukoinen transferriinireseptori (TfR) on hyvä raudanpuutteen mittari, ja sen taso on yleensä selvästi suurentunut raudanpuutteen yhteydessä (taulukko 2 «»4). Samanaikainen hemolyysi voi tosin nostaa TfR-tasoa (esim. talassemioiden yhteydessä). Pelkkä plasman rauta ei ole luotettava mittari rautatasapainosta. Transferriinin saturaatioprosentti on ensisijaisesti raudan kertymäsairauksien tutkimus, mutta matala taso kertoo myös raudanpuutteesta. Luuydinnäyte ei kuulu lasten raudanpuuteanemian diagnostisiin tutkimuksiin.
Kun lapsella tai nuorella todetaan raudanpuuteanemia, tulee arvioida raudanpuutteeseen johtaneet syyt. Jos raudanpuutteeseen on johtanut kuukautisvuoto, on syytä selvittää vuototaipumus (von Willebrandtin tauti) ja pyytää gynekologin tilannearvio (e-pillerit). Maidon kulutus on syytä selvittää ja sen juomiselle on hyvä asettaa selvä raja.
Perussyyn korjaamisen lisäksi potilas tarvitsee rautalisän. Lasten raudanpuuteanemian hoito toteutetaan lähes aina suun kautta otettavilla rautavalmisteilla (taulukko 3 «»5). Nestemäiset valmisteet saattavat värjätä hampaat ja soveltuvat siten lähinnä imeväisikäisille.
Rauta imeytyy parhaiten tyhjään vatsaan sitrusmehun kanssa otettuna, ja joidenkin tutkimusten mukaan annoksen ottaminen illalla parantaisi raudan imeytymistä. Raudan imeytymistä heikentävät kalsiumia sisältävien tai rautaa sitovien ruoka-aineiden ja juomien samanaikainen käyttö (maito, kahvi, tee).
Raudanpuuteanemian hoito kestää yleensä vähintään puoli vuotta (kuvio 2 «»6). Ensimmäiset 2-3 kuukautta tähtäävät anemian korjaamiseen ja toisessa vaiheessa tavoitteena on rautavarastojen täyttö. Rautahoitoa lopetettaessa on hyvä varmistaa rautavarastojen korjaantuminen tutkimalla verenkuvan lisäksi plasman ferritiinitaso. TfR:n tai transferriinin saturaatioarvoja ei tarvitse rutiininomaisesti kontrolloida. Murrosikäiset tytöt, joilla on runsaat kuukautiset, tai reilusti liikuntaa harrastavat nuoret (riittämätön saanti) voivat tarvita pienen jatkuvan rautalisän.
Jos rautahoito ei näytä onnistuvan, on palattava tarkistamaan raudanpuutteen perussyy (taulukko 1 «»1) ja tarkistettava, että diagnoosi on oikea. On myös varmistettava, että rautalisä on todella annettu. Joskus maku, ummetus tai vatsavaivat saavat lapsen kieltäytymään rautalisän käytöstä.
Anemia on raudanpuutteen myöhäinen ilmenemismuoto. Rauta on välttämätön alkuaine monissa elimistön prosesseissa, erityisesti kasvavalle ja kehittyvälle sikiölle ja lapselle. Raudanpuute vaikuttaa haitallisesti sikiön hermosolujen kehitykseen, aivojen välittäjäaineiden muodostumiseen ja hermojen myelinisaatioon (4,5). Epäedulliset vaikutukset voivat ilmetä lapsen neurologisessa kehityksessä (kognitiivinen, motorinen ja emotionaalinen kehitys), koulunkäynnissä (oppiminen, muisti sekä matemaattiset ja kielelliset taidot) ja jopa aikuisiän hyvinvoinnissa (4,6). Raudanpuute on joissakin tutkimuksissa yhdistetty myös kuumekouristuksiin ja affektikohtauksiin (7). Myös lihasten kasvuun ja immuniteettiin rautavajeella on negatiivinen vaikutus (8). Pica-oire sekä ruoansulatuskanavan oireet, kuten suun ja kielen tulehdus, ovat harvinaisia teollisuusmaiden lapsilla.
Lasten ja nuorten raudanpuuteanemian diagnostiikka ja hoito on yleensä suoraviivaista. Se voidaan hyvin toteuttaa perusterveydenhuollossa ja neuvolassa. Jos hoitovaste on riittämätön, on anemian diagnostiikkaa ja etiologisia selvittelyjä laajennettava (taulukko 1 «»1) ja varmistettava hoitomyöntyvyys. Tämä voi tapahtua porrastetusti perusterveydenhuollon ja erikoissairaanhoidon kesken.
Perusverenkuva tutkitaan lapsilta usein aivan muista syistä, ja olisi hyvä opetella tarkistamaan rutiininomaisessti hemoglobiini-, valkosolu- ja trombosyyttiarvojen lisäksi myös punasoluindeksit. Näin saataisiin kiinni jo varhainen raudanpuute ennen anemian kehittymistä.
Kiitokset LT Samuli Rouninojalle mikroskooppikuvasta.
Iron deficiency (ID) is the most common reason for development of anaemia during childhood. The diagnosis and care of iron deficiency anaemia (IDA) in children is usually straightforward. It can easily be carried out in primary health care. Unlike in adults, IDA in childhood is often related to dietary problems and not to potentially serious gastroenterological diseases. However, if response to iron supplementation treatment is poor, additional diagnostic tests and aetiological factors need to be taken into account. Blood samples are often investigated in children, for example during infectious diseases. It would be a good practice to also look routinely at the red blood cell indices in order to detect ID at an early stage, even before anaemia emerges.